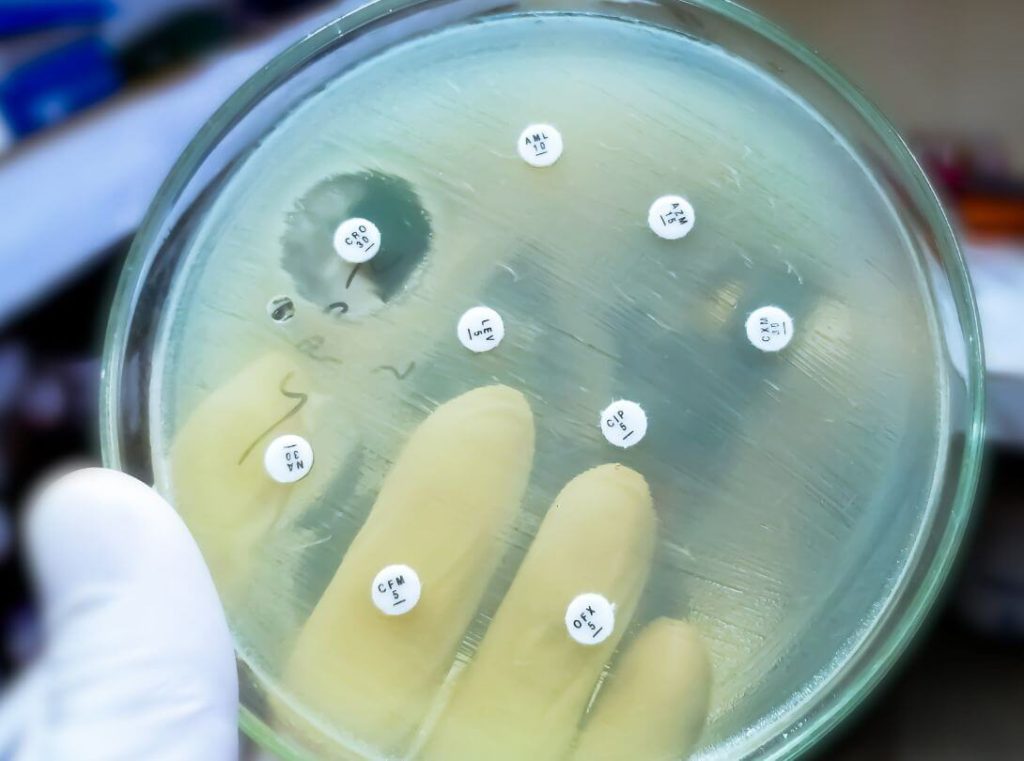

La resistencia a los antibióticos es una de las mayores amenazas para la salud pública en el siglo XXI. Detrás de este fenómeno están los genes de resistencia, secuencias de ADN que permiten a las bacterias evadir el efecto de los fármacos.
En este artículo, exploraremos qué son, cómo funcionan y por qué su propagación representa un desafío global para la medicina moderna.
1. ¿Qué son los genes de resistencia a antibióticos?
Definición básica y contexto microbiológico
Los genes de resistencia a antibióticos son segmentos de ADN que confieren a las bacterias la capacidad de sobrevivir ante la acción de estos medicamentos. Estos genes pueden estar presentes en el cromosoma bacteriano o en elementos genéticos móviles, como plásmidos o transposones. Desde una perspectiva evolutiva, estos genes no son nuevos: muchos existían en la naturaleza antes del uso clínico de los antibióticos. Sin embargo, el uso excesivo e inadecuado de estos fármacos ha acelerado su diseminación entre patógenos humanos.
Resistencia natural vs. resistencia adquirida
2. ¿Cómo se hacen resistentes las bacterias?
Mutaciones espontáneas
Las bacterias pueden volverse resistentes por cambios aleatorios en su ADN. Por ejemplo, una mutación en el gen gyrA de Mycobacterium tuberculosis reduce la afinidad por los antibióticos como las fluoroquinolonas, volviéndolas ineficaces.
Transferencia horizontal de genes
A diferencia de los humanos, las bacterias pueden "compartir" genes de resistencia entre ellas mediante:
Elementos genéticos móviles
3. Los genes de resistencia más peligrosos
Gen blaTEM (resistencia a penicilinas y cefalosporinas)
Este gen produce enzimas que destruyen antibióticos como la amoxicilina. Es común en E. coli y Klebsiella pneumoniae.
Gen vanA (resistencia a vancomicina)
Este gen, encontrado en Enterococcus faecium, altera el sitio de acción de la vancomicina, un antibiótico de último recurso. Su aparición en Staphylococcus aureus (VRSA) es especialmente alarmante.
Otros genes que debes conocer
4. Entornos donde se diseminan estos genes
Suelos y aguas residuales como reservorios
Las bacterias ambientales son una fuente natural de genes de resistencia. Las plantas de tratamiento de aguas pueden favorecer su intercambio entre microorganismos.
Uso de antibióticos en ganadería y agricultura
El empleo masivo de antibióticos en animales promueve la selección de bacterias resistentes, que luego llegan al humano mediante alimentos o contacto directo.
Ambientes hospitalarios y comunidades humanas
Los hospitales son focos críticos debido al uso intensivo de antibióticos. Sin embargo, la resistencia también se extiende en comunidades, como se observa con Neisseria gonorrhoeae multirresistente.
5. ¿Por qué es un problema grave en México?
Casos clínicos alarmantes
Bacterias "prioridad" para la OMS (grupo ESKAPE)
Costos para el sistema de salud
Las infecciones resistentes alargan hospitalizaciones, suben costos y ponen en riesgo cirugías o quimioterapias.
6. ¿Cómo podemos frenar este problema?
Usar antibióticos correctamente
Control ambiental y sanitario
7. Conclusión: Todos debemos actuar
Los genes de resistencia no son un juego. Si seguimos malgastando antibióticos, volveremos a una era sin cura para infecciones simples. Médicos, pacientes y autoridades debemos trabajar juntos.
¿Te interesa saber más sobre pruebas de resistencia? Contáctanos para asesoría en diagnóstico molecular.